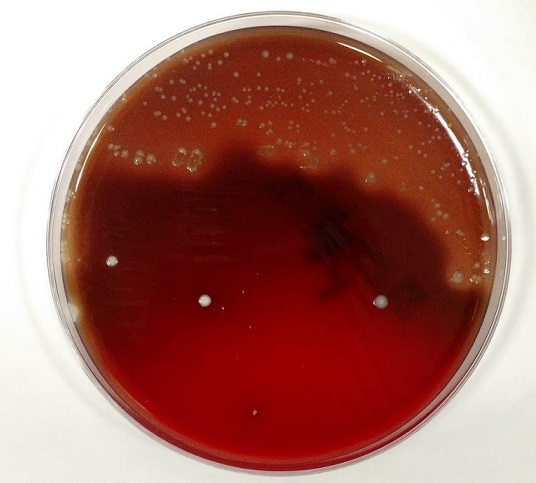
cloran1

Case History
A female in her 60s with no significant past medical history presented to the emergency department with continued abnormal uterine bleeding for the past two months. She reported never entering menopause. Patient complained of recent unintentional weight loss, shortness of breath, urinary frequency, and new-onset night-time fever and severe fatigue. Physical exam was notable for large uterus and left lower quadrant abdominal tenderness on palpation. Sterile speculum exam revealed a friable tissue extruding from the uterus and malodorous mixture of thin white purulent discharge and blood. Endometrial biopsy, tissue and blood cultures were collected. Labs were notable for normocytic anemia and leukocytosis. Urine analysis was suggestive of urinary tract infection. Pelvic ultrasound showed an enlarged uterus, thickened endometrium with mixed echogenicity. The patient was admitted to the hospital for work up of potential gynecological malignancy and was started on empiric antibiotic therapy for possible urinary tract infection.
The patient’s tissue Gram stain was notable for 2+ WBCs (PMNs) and 4+ gram negative rods. The predominant organism grew on 5% sheep blood and chocolate agars but there was no growth on the MacConkey agar (Image 1).


Discussion
The predominant organism was identified by MALDI-TOF MS as Pasteurella multocida. Given the microbiological findings, patient was further questioned but she denied having pet at home or contact with animals. The patient underwent a surgery to remove her uterus, both ovaries and Fallopian tubes. The gross pathological examination of her uterus revealed an exophytic endometrial lesion with extensive area of necrosis surrounding the lesion (Image 2A). Final microscopic pathological diagnosis was significant for a highly malignant and invasive tumor of the uterus (Image 2B) and active infection of her left Fallopian tube.
Here we present a rare case of a P. multocida intrauterine infection lacking history of animal exposure in the context of gynecologic malignancy. P. multocida is a small, non-motile, non-spore forming, aerobic and facultative anaerobic gram negative coccobacillus that is associated with animal exposure. [1] This organism is found in the digestive and respiratory tract of domesticated animals (cats, dogs, cattle, sheep etc.) as well as wild animals (lions, buffaloes, panthers etc.). The suggested hypothesis for transmission of Pasteurella to human involves close contact with the infected animal’s oral cavity. Thus, the most likely route of infection in humans is through direct animal bites or scratch, depositing the bacteria on compromised skin or if an infected animal lick on an exposed human mucosal surface [1, 2]. In the general population, P. multocida causes local infection that may progress to abscess formation, but bacteremia is uncommon. However, elderly patients and those with associated immunosuppressed states from chronic disease or cancer are at higher risk of more complicated severe infections [2].
The presented case highlights the importance of clinical microbiology in the setting of obtaining detailed history and conducting physical examination. Uncommon cases of P. multocida infection secondary to pet scratches or bite inducing genital infection and causing tubo-ovarian abscess have been reported. Similarly, rare cases of immune-compromised P. multocida bacteremia without history of animal contact have been described. The most likely explanation is the re-activation of previously asymptomatic colonization of the respiratory and gastrointestinal tract in the context of immunosuppression. As such, patients presenting with systemic Pasteurella infection without a documented animal exposure should undergo extensive evaluation in order to exclude the presence of an underlying immunodeficiency [1, 3-4].
References
- Weber DJ., Wolfson JS., Swartz MN., Hooper DC. Pasteurella multocida infections – report of 34 cases and review of literature. Medicine. 1984;63(3):133-54.
- Raffi F, Barrier J, Baron D, Drugeon HB, Nicolas F, Courtieu AL. Pasteurella multocida bacteremia- report of 13 cases over 12 years and review of the literature. Scand J Infecti Dis. 1987; 19:385-93.
- Kimura K., Hagiya H., Yamamoto N., Yoshida H., Akeda Y., Nishi I., Tomono K. Pasteurella multocida multiple intrapelvic abscesses in a young woman with uterine cervical cancer. J Infect Chemother (2018).
- Lukban JC., Baker MS. Pasteurella multocida isolation from a tuboovarian abscess. A case report. J Reprod Med 1995;40:603-5.

– Pouya Jamshidi, MD is a 1st year anatomic pathology resident at University of Chicago (NorthShore). Academically, Pouya has a particular interest in neuropathology and cellular basis of neuroplasticity. In his spare time, Pouya enjoys listening to classical music and opera.

-Erin McElvania, PhD, D(ABMM), is the Director of Clinical Microbiology NorthShore University Health System in Evanston, Illinois. Follow Dr. McElvania on twitter @E-McElvania.